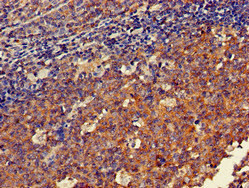

DOK3 Antibody
-
中文名稱:DOK3兔多克隆抗體
-
貨號:CSB-PA007019LA01HU
-
規格:¥440
-
圖片:
-
Western Blot
Positive WB detected in: Mouse heart tissue, Human placenta tissue
All lanes: DOK3 antibody at 3µg/ml
Secondary
Goat polyclonal to rabbit IgG at 1/50000 dilution
Predicted band size: 54, 24, 36, 25 kDa
Observed band size: 54 kDa -
Immunohistochemistry of paraffin-embedded human tonsil tissue using CSB-PA007019LA01HU at dilution of 1:100
-
Immunofluorescent analysis of A549 cells using CSB-PA007019LA01HU at dilution of 1:100 and Alexa Fluor 488-congugated AffiniPure Goat Anti-Rabbit IgG(H+L)
-
-
其他:
產品詳情
-
產品描述:
The DOK3 antibody is generated from rabbits immunized with a peptide corresponding to amino acids 1-146 of the recombinant DOK3 protein. It is a polyclonal antibody and occurs as an unconjugated IgG. Its purity is over 95% using protein G purified. It can react with human and mouse samples. The target protein DOK3 is an adaptor molecule preferentially expressed in hematopoietic cells, which act as a cell type–specific regulator downstream of various immune receptors, including TLR3, TLR4, and B cell receptor (BCR), during viral infection, LPS stimulation as well as plasma cell differentiation. And DOK3 is dispensable for the development of immune cells. And this DOK3 antibody can be used to detect the DOK3 protein in ELISA, WB, IHC, and IF analyses.
-
產品名稱:Rabbit anti-Homo sapiens (Human) DOK3 Polyclonal antibody
-
Uniprot No.:
-
基因名:
-
別名:Docking protein 3 antibody; DOK 3 antibody; DOK Like Protein antibody; Dok3 antibody; DOK3_HUMAN antibody; DOKL Pending antibody; Downstream of tyrosine kinase 3 antibody; p62 DOK Like Protein antibody
-
宿主:Rabbit
-
反應種屬:Human, Mouse
-
免疫原:Recombinant Human Docking protein 3 protein (1-146AA)
-
免疫原種屬:Homo sapiens (Human)
-
標記方式:Non-conjugated
本頁面中的產品,DOK3 Antibody (CSB-PA007019LA01HU),的標記方式是Non-conjugated。對于DOK3 Antibody,我們還提供其他標記。見下表:
-
克隆類型:Polyclonal
-
抗體亞型:IgG
-
純化方式:>95%, Protein G purified
-
濃度:It differs from different batches. Please contact us to confirm it.
-
保存緩沖液:Preservative: 0.03% Proclin 300
Constituents: 50% Glycerol, 0.01M PBS, pH 7.4 -
產品提供形式:Liquid
-
應用范圍:ELISA, WB, IHC, IF
-
推薦稀釋比:
Application Recommended Dilution WB 1:500-1:5000 IHC 1:20-1:200 IF 1:50-1:200 -
Protocols:
-
儲存條件:Upon receipt, store at -20°C or -80°C. Avoid repeated freeze.
-
貨期:Basically, we can dispatch the products out in 1-3 working days after receiving your orders. Delivery time maybe differs from different purchasing way or location, please kindly consult your local distributors for specific delivery time.
-
用途:For Research Use Only. Not for use in diagnostic or therapeutic procedures.
相關產品
靶點詳情
-
功能:DOK proteins are enzymatically inert adaptor or scaffolding proteins. They provide a docking platform for the assembly of multimolecular signaling complexes. DOK3 is a negative regulator of JNK signaling in B-cells through interaction with INPP5D/SHIP1. May modulate ABL1 function.
-
基因功能參考文獻:
- Mutations in DOK3 gene is associated with prostate cancer PMID: 26585945
- DOK2 and DOK3 expression was significantly reduced in HTLV-1-infected T cells. PMID: 27265473
- The Dok-3/Grb2 protein signal module attenuates Lyn kinase-dependent activation of Syk kinase in B cell antigen receptor microclusters PMID: 23223229
- absence of DOK3 increases LPS signaling, contributing to LPS-induced tolerance. Thus, DOK3 plays a role in TLR signaling during both naive and endotoxin-induced tolerant conditions PMID: 22761938
- Identification of DOK genes as lung tumor suppressors. PMID: 20139980
- The novel platelet adapter Dok-3 is tyrosine phosphorylated in an Src kinase-independent manner downstream of alphaIIbbeta3 in human platelets, leading to an interaction with Grb2 and SHIP-1. PMID: 19682241
- findings indicate that Dok-3 sequesters Grb2 from Shc and inhibits the Ras-Erk pathway downstream of PTKs PMID: 16436051
顯示更多
收起更多
-
亞細胞定位:Cytoplasm. Cell membrane; Peripheral membrane protein; Cytoplasmic side.
-
蛋白家族:DOK family, Type A subfamily
-
組織特異性:Expressed in spleen.
-
數據庫鏈接:
Most popular with customers
-
-
YWHAB Recombinant Monoclonal Antibody
Applications: ELISA, WB, IHC, IF, FC
Species Reactivity: Human, Mouse, Rat
-
-
-
-
-
-